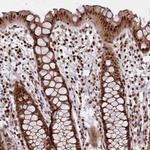
LEO1 Antibody in Immunohistochemistry (Paraffin) (IHC (P))

Search
Invitrogen
LEO1 Polyclonal Antibody
{{$productOrderCtrl.translations['antibody.pdp.commerceCard.promotion.promotions']}}
{{$productOrderCtrl.translations['antibody.pdp.commerceCard.promotion.viewpromo']}}
{{$productOrderCtrl.translations['antibody.pdp.commerceCard.promotion.promocode']}}: {{promo.promoCode}} {{promo.promoTitle}} {{promo.promoDescription}}. {{$productOrderCtrl.translations['antibody.pdp.commerceCard.promotion.learnmore']}}
产品信息
PA5-83513
种属反应
宿主/亚型
分类
类型
抗原
偶联物
形式
浓度
规格
纯化类型
保存液
内含物
保存条件
运输条件
RRID
产品详细信息
Immunogen sequence: SGQPSNKELF GDDSEDEGAS HHSGSDNHSE RSDNRSEASE RSDHEDNDPS DVDQHSGSEA PNDDEDEGHR SDGGSHHSEA EGSEKAHSDD EKWGREDKSD QSDDEKIQNS D
Highest antigen sequence indentity to the following orthologs: Rat - 82%, Mouse - 90%.
靶标信息
Prostaglandin-endoperoxide synthase (PTGS), also known as cyclooxygenase, is the key enzyme in prostaglandin biosynthesis, and acts both as a dioxygenase and as a peroxidase. There are two isozymes of PTGS: a constitutive PTGS1 and an inducible PTGS2, which differ in their regulation of expression and tissue distribution. This gene encodes the inducible isozyme. It is regulated by specific stimulatory events, suggesting that it is responsible for the prostanoid biosynthesis involved in inflammation and mitogenesis.
仅用于科研。不用于诊断过程。未经明确授权不得转售。
篇参考文献 (0)
生物信息学
蛋白别名: Leo1 Paf1/RNA polymerase II complex component; Leo1, Paf1/RNA polymerase II complex component, homolog; RDL; Replicative senescence down-regulated leo1-like protein; RNA polymerase-associated protein LEO1; unnamed protein product
基因别名: LEO1; RDL
UniProt ID: (Human) Q8WVC0
Entrez Gene ID: (Human) 123169